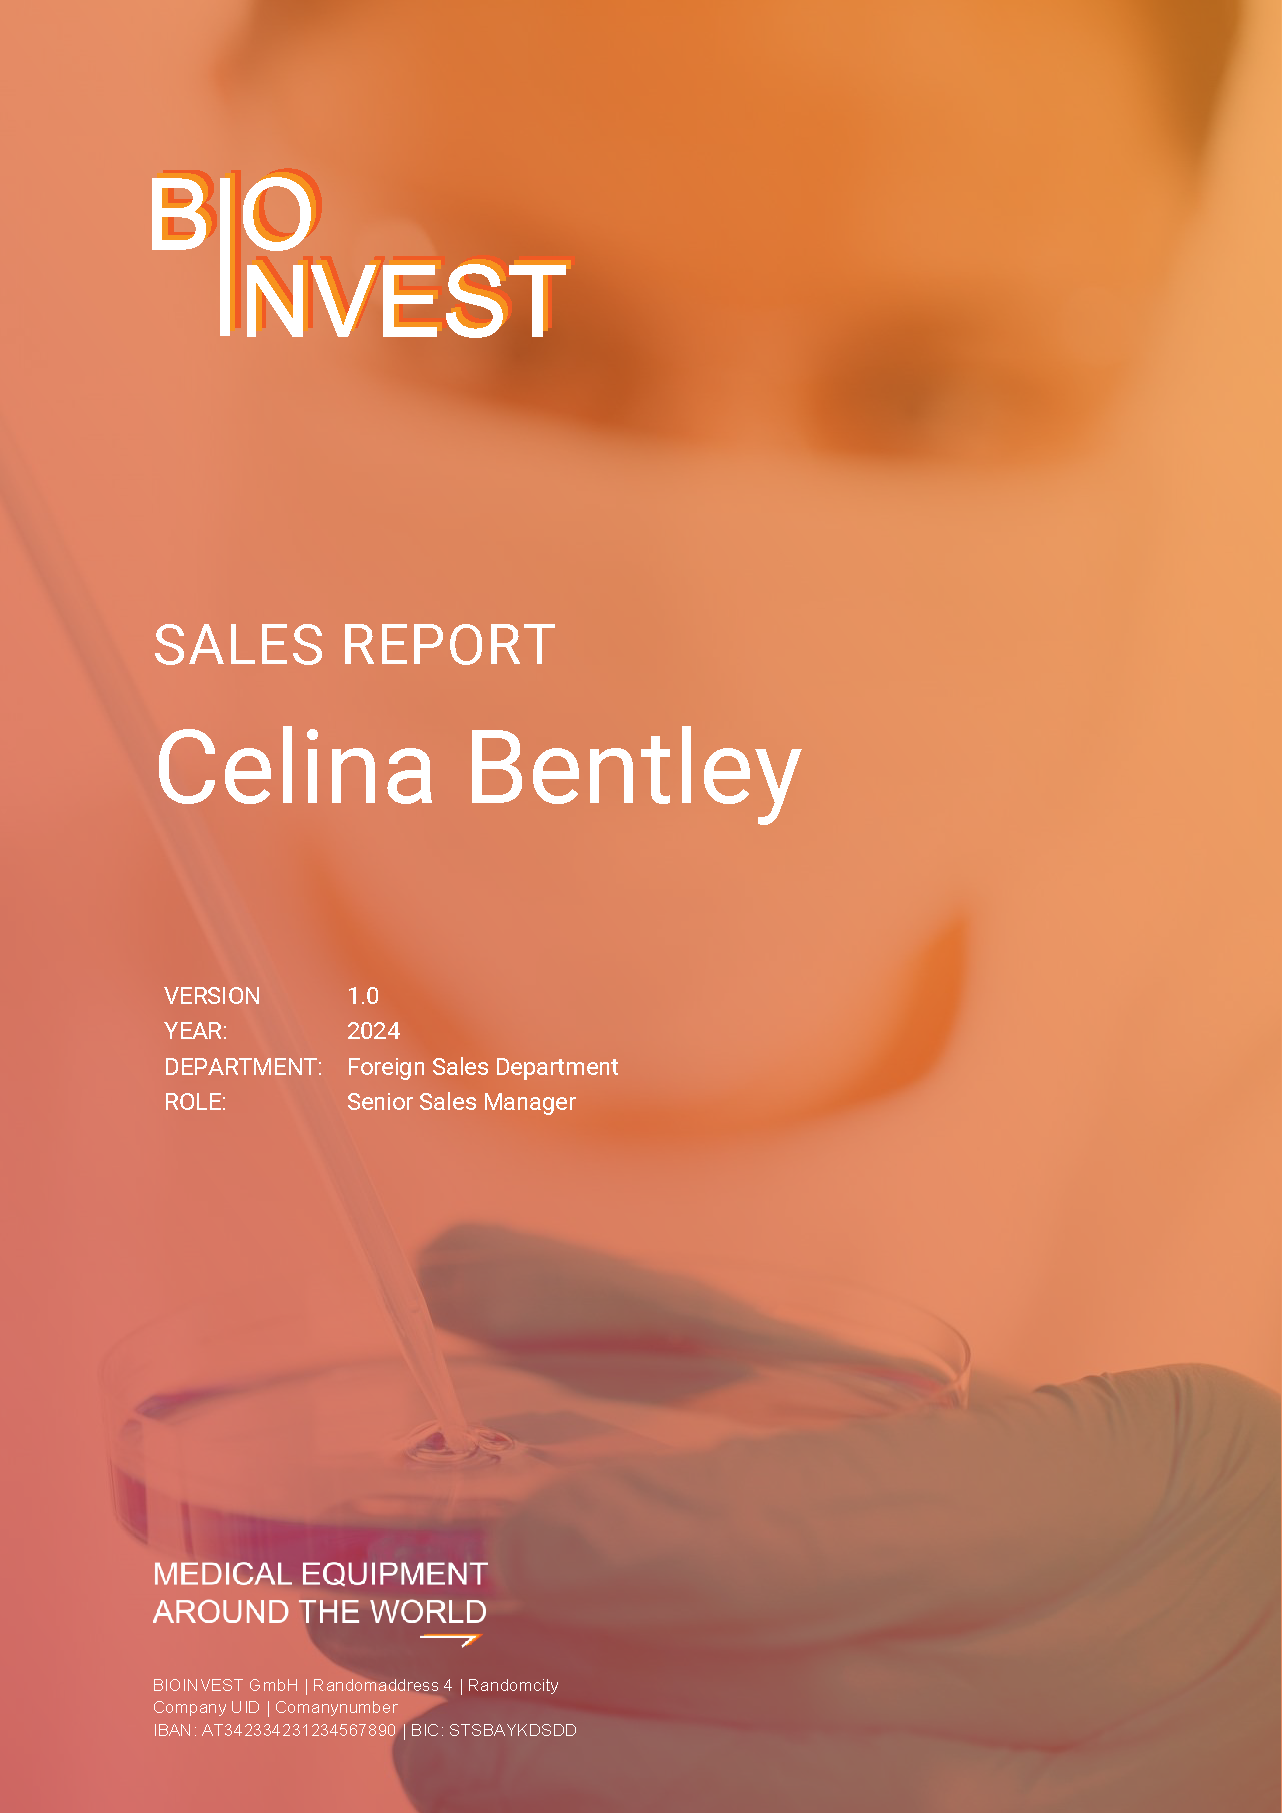
Sales Report

Templates
Templates

















 Templates
Templates